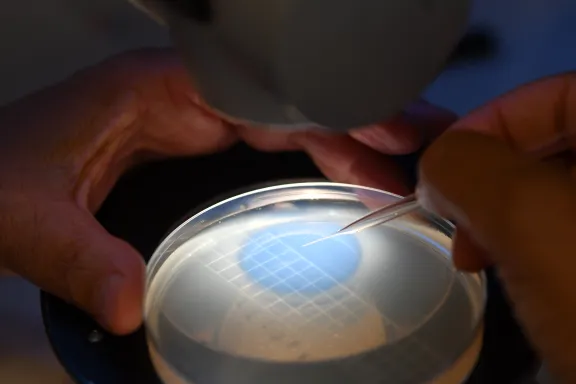

Mieux comprendre et guérir le Covid-19… La Fondation pour la recherche médicale a lancé un appel à la mobilisation pour répondre à cet impératif et soutenir trente-et-un projets prometteurs dans le cadre de la lutte contre cette maladie. Huit d’entre eux ont été financés par la Fondation Bettencourt Schueller. Ils répondent à plusieurs objectifs : mettre au point des modèles animaux, développer et tester des traitements et mieux comprendre la réponse immunitaire, la dispersion virale et les interactions entre le virus et la cellule.
Mettre au point des modèles animaux de la maladie
1. Améliorer la compréhension de l'infection via un modèle de macaque
Ce projet est coordonné par Roger Le Grand, Directeur du département Infectious diseases models for innovative therapies (IDMIT) au centre CEA Paris-Saclay. Son objectif : développer un modèle de macaque infecté par le virus Sars-CoV-2. Celui-ci permettra d'étudier les mécanismes de transmission, de dissémination et d’évolution de la maladie.
2. Mettre rapidement à disposition de la communauté scientifique des modèles animaux performants
Ce projet, qui a pour nom COVIDHUMICE, est coordonné par Bernard Malissen, Directeur du Centre d’immunophénomique à Marseille. Il vise à développer très rapidement cinq modèles de souris pour étudier la façon dont le virus Sars-CoV-2 infecte les cellules. Des vaccins et des thérapies antivirales pourront ensuite être testés grâce à ces modèles, qui permettront également d'approfondir les connaissances sur les mécanismes infectieux.
Développer et tester des traitements
3. Découvrir et développer de nouveaux antiviraux pour le contrôle et le traitement de l'infection
Le projet TargEnt-Covid-19 a été coordonné par Thomas Baumert, directeur de l'Institut de recherche sur les maladies virales et hépatiques de Strasbourg. Il a pour but d’identifier des facteurs cellulaires qui permettent au virus Sars-CoV-2 d’entrer dans ses cellules hôtes. Il s’agira également de mettre en évidence un ou plusieurs composés capables de bloquer cette action et qui pourraient constituer de futures molécules thérapeutiques.
Décrypter la réponse immune
4. Observer la réaction immunitaire face au sars-cov-2 pour découvrir des biomarqueurs et des pistes thérapeutiques
Le projet HARMONICOV a été coordonné par Michel Cogné, chercheur à l'Établissement Français du Sang de Bretagne. Il consiste à étudier avec précision la réaction immunitaire de l’organisme face à l’infection par le virus Sars-CoV-2. L'idée est de révéler des biomarqueurs pronostiques et thérapeutiques, utiles pour le suivi des patients. Ce travail participera également à l'identification d'anticorps qui serviront pour le développement d’une immunothérapie contre le virus.
Comprendre la dispersion virale
5. Analyse de l’évolution génétique du virus sars-cov-2 dans deux grands centres de référence parisiens
Benoît Visseaux, qui appartient à l'Unité « Infection, antimicrobiens, modélisation et évolution » de l'Hôpital Bichat-Claude-Bernard, a coordonné le projet PhyloCoV. Celui-ci a pour ambition d'effectuer le séquençage génétique de tous les sous-types de virus Sars-CoV-2 identifiés parmi les patients et le personnel médical des deux plus grands centres de référence pour COVID-19 de Paris. Ce travail permettra d’apporter des données essentielles pour mieux caractériser l’évolution du virus ainsi que sa transmission au sein des hôpitaux.
Comprendre les interactions entre le virus et les cellules
6. Explorer les mécanismes moléculaires de la réplication virale
Le projet IDISCOVR est coordonné par Marco Vignuzzi, responsable de l’équipe « Populations virales et pathogenèse » de l'Institut Pasteur, à Paris. Il vise à explorer les interactions moléculaires qui existent entre le virus Sars-CoV-2 et les cellules hôtes lors de l'infection. Cette étude pourrait déboucher sur l’identification de nouvelles cibles exploitables dans le cadre d’interventions préventives ou thérapeutiques contre la maladie.
7. Identifier les cellules initialement infectées par le sars-cov-2 et caractériser leur réponse
Isabelle Schwartz, responsable de l’équipe « Vaccins Immunopathologie Immunomodulation » à l'Institut national de recherche pour l’agriculture, l’alimentation et l’environnement, a coordonné le projet ICARE. Celui-ci a pour but d’identifier les types cellulaires initialement ciblés par le virus Sars-CoV-2 grâce à l’utilisation de modèles de poumons humains. L'idée est d’étudier les réponses précoces de ces cellules à l’infection. Ce travail pourrait apporter des informations précieuses pour guider la mise au point de stratégies thérapeutiques visant à bloquer l’entrée du virus dans les cellules.
8. Étudier une étape clé de la multiplication du sars-cov-2 dans la cellule
Le projet coronaIRES est coordonné par Franck Martin, de l'équipe « Évolution des systèmes d’initiation de la traduction chez les eucaryotes » à l’Institut de Biologie Moléculaire et Cellulaire de Strasbourg. Celui-ci vise à étudier un mécanisme moléculaire qui a lieu lors de la multiplication du Sars-CoV-2 dans la cellule : l’expression du matériel génétique viral. Explorer ce phénomène permettra de développer des molécules capables de le bloquer, en vue de lutter contre l’infection.
En savoir plus sur le soutien de la Fondation dans le domaine des sciences de la vie
La Fondation Bettencourt Schueller soutient et encourage les chercheurs qui contribuent au rayonnement de notre pays dans les sciences de la vie. Cet engagement est le premier de la Fondation depuis sa création en 1987. S’il est principalement orienté vers la recherche fondamentale, sa finalité est l’amélioration de la santé humaine.
Voir tous les projets dans le domaine des sciences de la vie